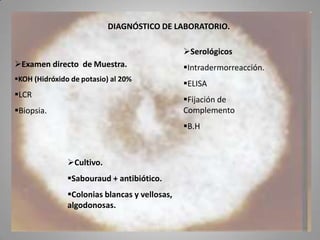
DIAGNÓSTICO DE LABORATORIO.
Serológicos
Examen directo de Muestra.

Intradermorreacción.

KOH (Hidróxido de potasio) al 20%

ELISA

LCR

Fijación de
Complemento

Biopsia.

B.H

Cultivo.

Sabouraud + antibiótico.
Colonias blancas y vellosas,
algodonosas.

Este documento describe la coccidioidomicosis, una micosis profunda causada por el hongo Coccidioides. Se presentan los siguientes puntos: la distribución geográfica de la enfermedad, la epidemiología, patogenia, cuadros clínicos como la forma primaria pulmonar y cutánea, diagnóstico, tratamiento y profilaxis. También se mencionan otros hongos como Histoplasma capsulatum que causa la histoplasmosis.